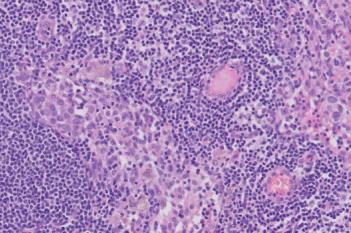
Metastasis Detection, AI
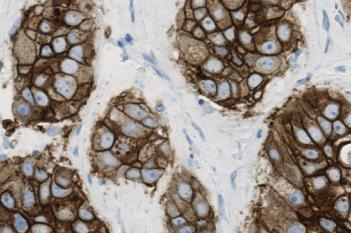
HER2 APP, Breast Cancer

We bring you next-level AI driven precision pathology allowing you to analyze images with high accuracy and speed, so you can spend more time focusing on the interpretation of the results.
Precision
A precise diagnosis must deliver certainty, which emerges from reliable and consistent results.
Visiopharm’s IVDR certified APPs have been validated on thousands of tissue sections and deliver the precision and reproducibility needed for decision making.
Decision support for pathologists
CE-IVD APP results are presented as an overlay on the images for easy review. All virtual slides associated with a patient case are automatically synchronized and linked for simultaneous viewing and presented to the pathologist. Benefit from digital image analysis for objective, quantified and standardized analysis.
Help compensate the shortage of pathologists
CE-IVD APPs allow your qualified staff to handle all technical aspects of image analysis in a standardized way, with low inter-operator variability. The results are then sent to the laboratory information system for final pathologist review.
High reproducibility
For our breast cancer marker APPs we have documented repeatability and reproducibility in diagnostic readings.
Scan with confidence
In Europe we offer various in vitro diagnostic use slide scanners to meet your slide throughput. Implement Visiopharm Scanners by Hamamatsu to get fast, reliable whole slide imaging, ready for image analysis.
See all scanners

“Artificial intelligence supports us in two ways:
It allows for better and much more accurate reading of known biomarkers, which, despite the development of new staining techniques, remains challenging.
Next, it will give us unique opportunities to develop new biomarkers that can better help us select patients for different types of treatment.
We expect that artificial intelligence will revolutionize the way pathologists work today and improve diagnostic quality. “
Professor Torben Steiniche, MD, Department of Pathology, Aarhus University Hospital, DK
Certified under IVDR
Our Diagnostic APPs
Explore our CE-IVD APPs for use in diagnostic workflows.
Show all CE-IVD APPs
(CE-IVD APPs are for in vitro diagnostic use in EU/UK. Not for sale in the USA.)

“I have not personally seen a case where I disagreed with the software.”
Jan Lindebjerg, Vejle Hospital, Denmark
Start using AI-based image analysis
Our CE-IVD marked APPs for AI-based image analysis can replace manual steps in your diagnostic workflow. Developed with pathologists and rigorously tested for each indication, the list of applications is constantly growing. With convenient subscription-based software editions, you can get access to the entire portfolio of diagnostic APPs.
Digitize your pathology workflow
We understand that going digital may feel like having to tackle an “uphill battle”. But don’t worry, we’ve got you covered: Visiopharm has extensive experience in digitizing research laboratories as well as entire hospitals. Over the last 10 years we have had the privilege of being part of implementing digital pathology solutions at around 35 pathology labs in Scandinavia and we are glad to share our experiences and learnings with you.
Fits your purpose
Visiopharm solutions offer a set of diverse tools that are tailored to fit your exact needs. CE-IVD APPs are designed for cancer diagnostics. Additional modules can be added for users who wish to develop a lab-developed test.

“Where we have seen the most significant impact of diagnostic digital breast pathology is in conjunction with HER2 assessment. The algorithm is simply better at discriminating between amplified and non-amplified cases, which means that we are seeing fewer inconclusive (2+) cases requiring additional (reflex) testing which is HER2-FISH testing, here at Vejle. This typically takes at least an additional day, and cost around EUR 250 per test (incl manual labor).”
Jan Lindebjerg, Vejle Hospital, Denmark

Explore our scanners
Get detailed information on our scanning solutions.
Resources
Browse our guides, webinars and posters.